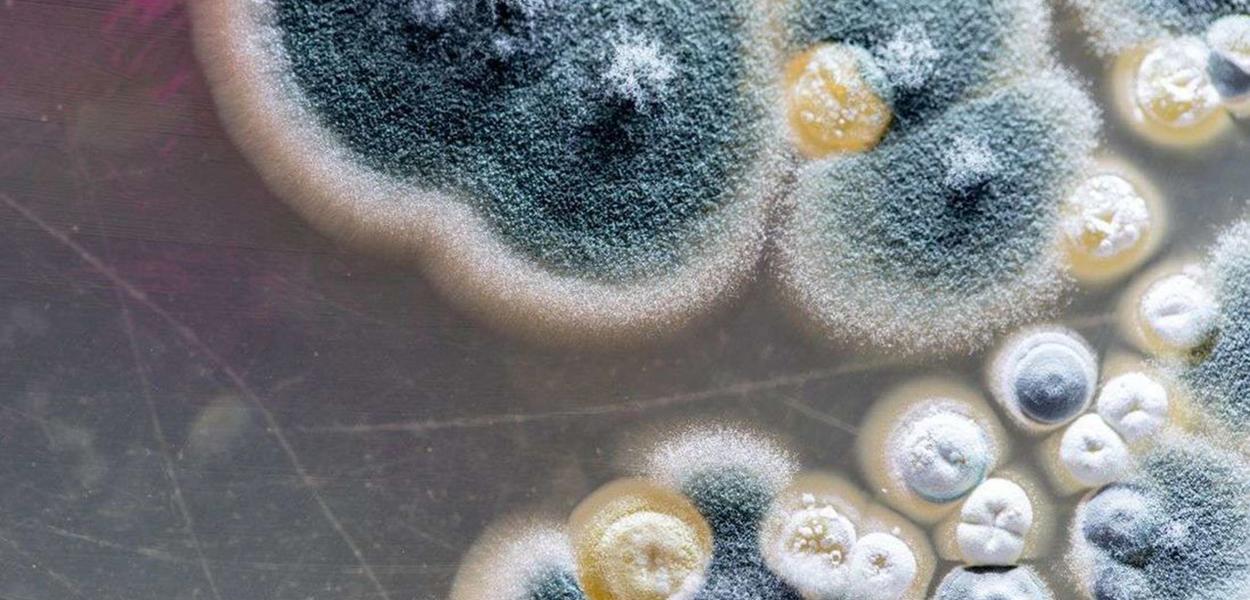

Pernambuco registra primeiro caso de fungo negro em paciente que teve Covid-19
De acordo com o infectologista Tiago Ferraz, a infecção aconteceu trinta dias após os primeiros sintomas da Covid-19 em uma paciente de 59 anos. Este ano o Brasil notificou 29 casos da mucormicose, doença conhecida como fungo negro
✅ Receba as notícias do Brasil 247 e da TV 247 no canal do Brasil 247 e na comunidade 247 no WhatsApp.
247 - O estado de Pernambuco registrou, neste domingo (6), um caso de mucormicose, infecção conhecida como "fungo negro", em uma paciente diagnosticada com a Covid-19.
De acordo com a Secretaria Estadual de Saúde (SES-PE), a ocorrência foi notificada pelo Hospital Universitário Oswaldo Cruz (Huoc) em uma paciente de 59 anos, que mora em Casinhas, no Agreste do Estado. As informações foram publicadas pelo jornal Folha de Pernambuco.
Infectologista do Huoc, Tiago Ferraz disse que a paciente “possui fatores de risco clássicos para infecção por esse fungo e a associação com a Covid-19 ainda está sendo estudada, visto que a infecção veio a acontecer trinta dias após os sintomas da Covid e quando já estava curada”. “Essa paciente já está recebendo o tratamento medicamentoso, já foi submetida a uma cirurgia, que fez a maior parte da higiene cirúrgica para a retirada desse fungo”, afirmou.
A secretaria informou que a mulher "é diabética, hipertensa, asmática e obesa, e está internada em enfermaria no Huoc, desde a última sexta-feira (4), consciente e com quadro de saúde estável".
No Brasil foram notificados 29 casos da mucormicose este ano. Pelo menos quatro são investigados pela associação com a Covid-19.
Inscreva-se no canal de cortes da TV 247 e saiba mais:
Assine o 247, apoie por Pix, inscreva-se na TV 247, no canal Cortes 247 e assista:
Comentários
Os comentários aqui postados expressam a opinião dos seus autores, responsáveis por seu teor, e não do 247